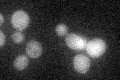
YLR189C
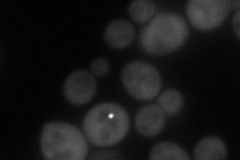
YLR189C
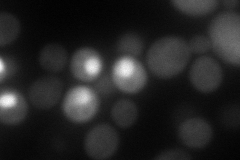
YLR189C
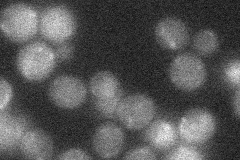
YLR189C
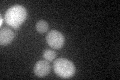
YLR189C
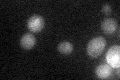
YLR189C

View description
UDP-glucose:sterol glucosyltransferase, conserved enzyme involved in synthesis of sterol glucoside membrane lipids; in contrast to ATG26 from P. pastoris, S. cerevisiae ATG26 is not involved in autophagy
Localization:
Intensity:
Fold change:
Significance:
-
C’ GFP library in SD
cytosol20.35 -
N' NOP1pr-GFP in SD
cytosol72.1818 -
N' TEF2pr-mCherry in SD
cytosol73.1007 -
N' NATIVEpr-GFP in SD
below threshold23.1274 -
N' TEF2pr-VC and Cyto-VN in SD

#N/A0 -
C’ GFP library in SD+DTT
cytosol20.611.01No -
C’ GFP library in SD+H2O2

cytosol25.21.23No -
C’ GFP library in Starvation Media
cytosol27.141.33No -
C’ GFP library on the background of Pup2-DaMP

cytosol -
C’ GFP library on the background of CCT mutant

cytosol27.41851.34684No
